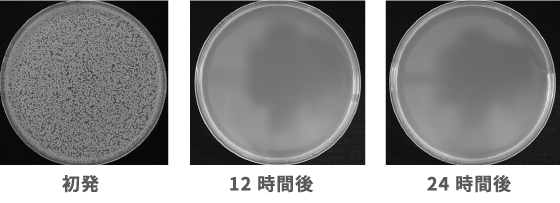
PROTECT47 Ag+

マイストア
変更
お店で受け取る
(送料無料)
配送する
納期目安:
2026.04.02 19:31頃のお届け予定です。
決済方法が、クレジット、代金引換の場合に限ります。その他の決済方法の場合はこちらをご確認ください。
※土・日・祝日の注文の場合や在庫状況によって、商品のお届けにお時間をいただく場合がございます。
銀イオンスチーム PROTECT 47 Ag + 銀イオンスチーマー PROTECT47Ag+ - メルカリの詳細情報
銀イオンスチーマー PROTECT47Ag+ - メルカリ。PROTECT47 Ag+。PROTECT47 Ag+。気になる場所にPROTECT47 Ag+飲食店のテーブル、カラオケBOX、オフィス、車内、旅行・出張先のホテル、トイレ、他パーソナルスペースを空間除菌します。PROTECT47 Ag+は、除菌をするための薬品などは一切使用しません。水だけで銀イオン水をつくり、除菌・消臭します。化学成分、有害物質、人工色素、合成香料、防腐剤が一切含まれず、薬品も使用しませんので妊婦さん、乳幼児、お肌の弱い方、全ての方に安心してお使いいただけます。・ボトル容量 360ml・1台で6m²~9m²をカバーします。・約4時間充電(USB 充電) 6.5時間/1箇所稼働 3時間/2箇所稼働・必ず塩素の入っていない水をご使用ください。さらに、アトピーや喘息などアレルギーをお持ちの方にも黄色ブドウ球菌はアトピーを悪化させるといわれています。銀イオンは黄色ブドウ球菌に対して、高い除菌効率が確認されました。PROTECT47 Ag+。プロ用セニングシザー切れ味◎理美容師ブレンダーブレンディング✨️トリマーペット可。TRTASSER シザー 美容師 右利き用。スパスパ快適に切れる理美容師サロン用セニングシザー♪トリマートリミングペット可。光 HIKARI セニング シザー。抜け感の良いプロ用セニングシザー理美容師+トリマートリミングペットママミング可。美容師カット用シザー3本セニング1本
ベストセラーランキングです
近くの売り場の商品
カスタマーレビュー
オススメ度 4.8点
現在、3118件のレビューが投稿されています。